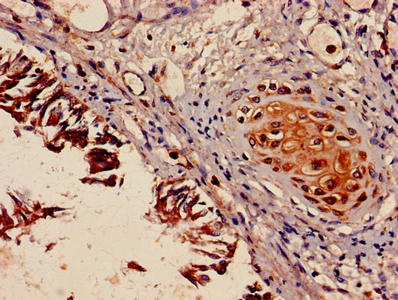

MYH9 Antibody
-
中文名稱:MYH9兔多克隆抗體
-
貨號:CSB-PA01405A0Rb
-
規格:¥440
-
圖片:
-
Immunohistochemistry of paraffin-embedded human kidney tissue using CSB-PA01405A0Rb at dilution of 1:100
-
Immunofluorescent analysis of Hela cells using CSB-PA01405A0Rb at dilution of 1:100 and Alexa Fluor 488-congugated AffiniPure Goat Anti-Rabbit IgG(H+L)
-
Immunohistochemistry of paraffin-embedded human lung tissue using CSB-PA01405A0Rb at dilution of 1:100
-
-
其他:
產品詳情
-
產品名稱:Rabbit anti-Homo sapiens (Human) MYH9 Polyclonal antibody
-
Uniprot No.:
-
基因名:
-
別名:BDPLT 6 antibody; BDPLT6 antibody; Cellular myosin heavy chain antibody; Cellular myosin heavy chain type A antibody; DFNA 17 antibody; DFNA17 antibody; EPSTS antibody; FTNS antibody; MGC104539 antibody; MHA antibody; MYH 2A antibody; MYH 9 antibody; MYH2A antibody; MYH9 antibody; MYH9_HUMAN antibody; MYHas8 antibody; MyHC 2A antibody; MyHC IIa antibody; MyHC2A antibody; MyHCIIa antibody; MYHSA 2 antibody; MYHSA2 antibody; Myosin 9 antibody; Myosin heavy chain 9 antibody; Myosin heavy chain 9 non muscle antibody; Myosin heavy chain antibody; Myosin heavy chain non muscle IIa antibody; Myosin heavy chain nonmuscle IIa antibody; Myosin heavy polypeptide 2 antibody; Myosin heavy polypeptide 9 non muscle antibody; Myosin-9 antibody; Myosin9 antibody; NMHC II A antibody; NMMHC A antibody; NMMHC II a antibody; NMMHC II-a antibody; NMMHC IIA antibody; NMMHC-A antibody; NMMHC-IIA antibody; NMMHCA antibody; Non muscle myosin heavy chain A antibody; Non muscle myosin heavy chain antibody; Non muscle myosin heavy chain II A antibody; Non muscle myosin heavy polypeptide 9 antibody; non-muscle IIa antibody; Non-muscle myosin heavy chain A antibody; Non-muscle myosin heavy chain IIa antibody; Nonmuscle myosin heavy chain A antibody; Nonmuscle myosin heavy chain II A antibody; type A antibody
-
宿主:Rabbit
-
反應種屬:Human
-
免疫原:Recombinant Human Myosin-9 protein (2-241AA)
-
免疫原種屬:Homo sapiens (Human)
-
標記方式:Non-conjugated
本頁面中的產品,MYH9 Antibody (CSB-PA01405A0Rb),的標記方式是Non-conjugated。對于MYH9 Antibody,我們還提供其他標記。見下表:
-
克隆類型:Polyclonal
-
抗體亞型:IgG
-
純化方式:>95%, Protein G purified
-
濃度:It differs from different batches. Please contact us to confirm it.
-
保存緩沖液:Preservative: 0.03% Proclin 300
Constituents: 50% Glycerol, 0.01M PBS, PH 7.4 -
產品提供形式:Liquid
-
應用范圍:ELISA, IHC, IF
-
推薦稀釋比:
Application Recommended Dilution IHC 1:20-1:200 IF 1:50-1:200 -
Protocols:
-
儲存條件:Upon receipt, store at -20°C or -80°C. Avoid repeated freeze.
-
貨期:Basically, we can dispatch the products out in 1-3 working days after receiving your orders. Delivery time maybe differs from different purchasing way or location, please kindly consult your local distributors for specific delivery time.
-
用途:For Research Use Only. Not for use in diagnostic or therapeutic procedures.
相關產品
靶點詳情
-
功能:Cellular myosin that appears to play a role in cytokinesis, cell shape, and specialized functions such as secretion and capping. Required for cortical actin clearance prior to oocyte exocytosis. Promotes cell motility in conjunction with S100A4. During cell spreading, plays an important role in cytoskeleton reorganization, focal contact formation (in the margins but not the central part of spreading cells), and lamellipodial retraction; this function is mechanically antagonized by MYH10.
-
基因功能參考文獻:
- These results indicate that nonmuscle myosin heavy chain-IIs interact with sodium channel alpha subunits subunits in an isoform-dependent manner and influence their functional properties. PMID: 29956586
- In neutrophilic leucocytes from MYH9-related disease patients NMIIa inclusions are accompanied by increased lipid storage in droplets, suggesting that NMIIa dysfunction may contribute to lipid imbalance in man. PMID: 28361956
- A missense mutation (c.1124C>T:p.S375F) was found in a congenital thrombocytopenia patient and his affected mother. It was associated with abnormal neutrophil NMMHC-IIA localization. PMID: 28293712
- Our results suggest that MYH9 rs3752462 is significantly associated with an increased risk of diabetic kidney disease in Chinese Han individuals. PMID: 29862302
- Results suggest that coupling between actin and microtubule cytoskeletons driven by Myosin II and KIF20A ensures the spatial coordination between RAB6-positive vesicles fission from Golgi/trans-Golgi network membranes and their exit along microtubules. PMID: 29093437
- These results suggest that cytoplasmic multimolecular protein complexes containing myosin-9 and tropomyosin are involved in the regulation of cellular response to LYSOPHOSPHATIDIC ACID. PMID: 30199160
- miR-647 functions as a tumor metastasis suppressor in gastric cancer by targeting SRF/MYH9 axis. PMID: 28900514
- MYO18A has the potential to form a multiprotein complex that links the Golgi apparatus to F-actin, which regulates muscle integrity and function during early development PMID: 27824130
- Report that PTCSC2 binds myosin-9 (MYH9). In a bidirectional promoter shared by FOXE1 and PTCSC2, MYH9 inhibits the promoter activity in both directions. This inhibition can be reversed by PTCSC2, which acts as a suppressor. PMID: 28049826
- demonstrated that though the targeted integration site for exogenous genes is shifted to MYH9 intron 2 (about 500bp downstream exon 2), the high HR efficiency and the endogenous MYH9 gene integrity are not only preserved, but the expected expression of the inserted gene(s) is observed in a pre-designed set of experiments conducted in mouse ES cells PMID: 29438440
- These distinct functions of NMIIA and NMIIB might promote intrinsic and directed migration of normal human fibroblasts. PMID: 29486156
- ALPK1 is a kinase that participates in the regulation of Golgi-derived TNF-alpha trafficking through myosin IIA phosphorylation in the inflammation of gout. PMID: 27169898
- we present high MYH9 expression as a reliable and powerful prognostic factor for patients with AML. PMID: 27437869
- Mutations of MYH9 cause MYH9-RD, a form of congenital thrombocytopenia characterized by giant platelets and no platelet functional abnormalities. PMID: 28368695
- Findings suggest that the tumor suppressor capability of wtp53 is dependent upon functional NMIIA and that the invasive phenotype of high-risk mutp53 is independent of NMIIA. PMID: 28160562
- Heterozygous deletional mutation (c.5803delG) in exon 41 of the MYH9 gene is associated with inherited thrombocytopenia. PMID: 28604953
- cytokinesis failure in megakaryocytes is the consequence of both the absence of NMIIB and a low RhoA activity that impairs NMIIA localization at the cleavage furrow through increased actin turnover. PMID: 27737892
- The loss of junctional NMIIA, upon Coronin 1B knockdown, perturbed RhoA signaling. PMID: 27650961
- Results identified nonsynonymous variants in MYH9 and ABCA4 to be the most frequent risk loci in nonsyndromic orofacial clefts in the Taiwanese population. PMID: 27527345
- Our study is the first to identify genetic predisposition to transplant renal artery stenosis in patients with MYH9 risk allelic variants (rs4821480, rs4821481, rs3752462, rs11089788, rs136211, rs5756168, rs2032487, and rs2239784) PMID: 27496447
- The hearing impairment associated with MYH9 disorder in this family was characterized as adult onset, progressive, and high-frequency dominant. Hematological manifestations of MYH9 disorder show complete penetrance, whereas extra-hematological manifestations show incomplete penetrance and variable expressivity in this family. PMID: 26942920
- mass spectrum followed by immunoprecipitation identified non-muscle myosin heavy chain-IIA (NMMHC-IIA) as the CXCR4-interacting protein. Furthermore, pharmaceutical inhibition of NMMHC-IIA by blebbistatin dampened the nuclear translocation of CXCR4 as well as the metastatic capacity of RCC cells PMID: 27634189
- The rs3752462 polymorphism of MYH9 is associated with high systolic blood pressure in patients with CKD. The T allele in the dominant model was associated with an elevated risk for high systolic blood pressure . PMID: 27924804
- The Raf-ERK1/2 signaling pathway is involved in regulation of NMIIA by DT-13. PMID: 27374701
- The tumor microenvironment can regulate NMIIA in cancer cells. PMID: 27350172
- HhnRNP-K-mediated regulation of NMHC IIA mRNA translation contributes to the control of enucleation in erythropoiesis. PMID: 26823606
- Data show that a heterozygous missense mutation c.4270G>A (p.Aspl841Asn) in exon 30 of the non-muscle myosin heavy chain 9 (MYH9) gene was identified in all affected members from thE family. PMID: 27577209
- the present study indicated that knockdown of NMIIA inhibited the migration and invasion of gastric cancer cells, which may be, at least in part, mediated via the JNK signaling pathway. PMID: 26719067
- Knocking down myosin-9 or promoting protein S-glutathionylation by knocking down glutaredoxin-1 inhibited the death of airway smooth muscle cells by heating to simulate bronchial thermoplasty PMID: 26499037
- Severity and progression of sensorineural hearing loss appeared to depend on the specific NMMHC-IIA mutation in patients with MYH9-related disease. PMID: 26226608
- 7 members in 3 generations of a family had macrothrombocytopenia without Alport syndrome, and they all had a p.A95V mutation in exon 1 of MYH9. This affects the motor domain. PMID: 26861218
- heterozygotic form (allele A) of the MYH9 gene could be considered a very early marker, a new risk factor for the appearance of CKD, or a sign of renal frailty in elderly people. PMID: 26152646
- concordant with the genetic interaction observed in sickle cell disease patients, APOL1 G2 reduces myh9 expression in vivo, suggesting a possible interaction between the altered APOL1 and myh9. PMID: 26147622
- myosin IIA and IIB heavy chains play distinct and non-redundant roles in matrix remodeling PMID: 26136073
- Inhibition of NMMHC IIA impedes TF expression and venous thrombosis via Akt/GSK3beta-NF-kappaB signalling pathways in the endothelium both in vitro and in vivo. PMID: 25881103
- revealed that MYH9 is expressed in a subset of NSCLC with a more malignant nature, and its expression is an indicator of a poorer survival probability PMID: 25826333
- R705H mutation of MYH9 is associated with MYH9-related disease characterized by hearing impairment, thrombocytopenia, giant platelets, leukocyte inclusions, and mild to moderate elevation of some liver enzymes PMID: 24890873
- Data show that myosin II supports a stable Rho zone at the at E-cadherin junctions. PMID: 26368311
- MYH9 gene polymorphisms may be associated with multiple cerebrovascular blood flow phenotypes in Chinese patients with type 2 diabetes PMID: 25730040
- High myosin-9 expression is associated with esophageal squamous cell carcinoma. PMID: 25605255
- One complicating factor in this case is the diagnosis of MYH9RD in this patient. PMID: 25424224
- A novel MYH9 mutation in a patient with MYH9 disorders and platelet size-specific effect of romiplostim on macrothrombocytopenia. PMID: 26051904
- MYH9 p.R1165C mutation is associated with MYH9 Disorder. PMID: 26056797
- we tested the effect of loss of MYH9 expression in podocytes in vitro, and found that it was necessary for cytoskeletal organization PMID: 24949636
- Whereas most nonmuscle myosin IIA (MIIA) at the leading edge assembled into dorsal contractile arcs, a substantial subset assembled in or was captured within maturing focal adhesions, and this behavior was promoted by active Rac1. PMID: 25544611
- the role of myosin IIA and its specific kinase, myosin light chain kinase, during Shigella intercellular spreading was investigated in HeLa cells PMID: 24989342
- A novel mechanism of regulation of NMHC-IIA activity relying on the phosphorylation of Tyr-158 by Src. PMID: 25635050
- These findings indicate that overexpression of NMIIA may contribute to the progression and poor prognosis of GC. PMID: 23203126
- Matrix stiffness couples to myosin-II activity to promote lamin-A,C dephosphorylation at Ser22, which regulates turnover, lamina physical properties, and actomyosin expression. Lamin-A,C phosphorylation is low in interphase versus dividing cells. PMID: 25127216
- The role of myosin II in shape control of invasive cells migrating in 3D collagen gels, was studied. PMID: 25621949
顯示更多
收起更多
-
相關疾病:May-Hegglin anomaly (MHA); Sebastian syndrome (SBS); Fechtner syndrome (FTNS); Epstein syndrome (EPSTNS); Deafness, autosomal dominant, 17 (DFNA17); Macrothrombocytopenia and progressive sensorineural deafness (MPSD)
-
亞細胞定位:Cytoplasm, cytoskeleton. Cytoplasm, cell cortex. Cytoplasmic vesicle, secretory vesicle, Cortical granule.
-
蛋白家族:TRAFAC class myosin-kinesin ATPase superfamily, Myosin family
-
組織特異性:In the kidney, expressed in the glomeruli. Also expressed in leukocytes.
-
數據庫鏈接:
Most popular with customers
-
-
YWHAB Recombinant Monoclonal Antibody
Applications: ELISA, WB, IHC, IF, FC
Species Reactivity: Human, Mouse, Rat
-
Phospho-YAP1 (S127) Recombinant Monoclonal Antibody
Applications: ELISA, WB, IHC
Species Reactivity: Human
-
-
-
-
-